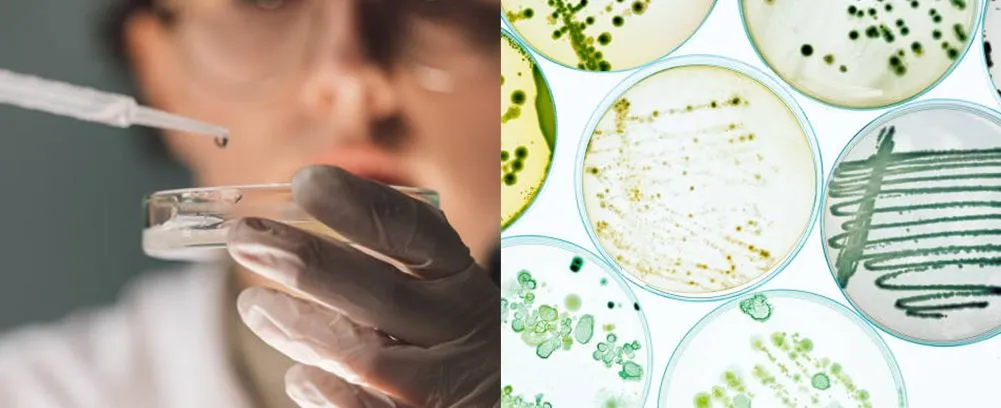
Laboratory glass petri dish 100mm application

Mias Petri Gloine Saotharlainne 100mm
Is éard atá i mias petri, ar a dtugtar pláta petri nó mias saothraithe cille, earraí saotharlainne do shaothrúchán cille agus miocróbach earraí saotharlainne atá déanta as clúdach agus bun cothrom cruinn nó cruth cearnach. Go ginearálta, tá mias petri déanta as gloine agus plaisteach ard borosilicate.
Cur síos
Mias petri gloine 100mm de ghloine ard-borosilicate
Is éard atá i mias petri, ar a dtugtar pláta petri nó mias saothraithe cille, earraí saotharlainne do shaothrúchán cille agus miocróbach earraí saotharlainne atá déanta as clúdach agus bun cothrom cruinn nó cruth cearnach. Go ginearálta, tá mias petri déanta as gloine agus plaisteach ard borosilicate. Tá sé ar cheann de na míreanna is coitianta i saotharlanna bitheolaíochta.
Táirgeann Jiangsu Guide Medlab go leor méideanna miasa petri gloine borosilicate ard bunaithe ar chaighdeáin ISO. Tá LOGO saincheaptha, méideanna agus pacáiste inghlactha. Tá na miasa Petri pacáilte i gcartáin roctha de réir GB/T 6543; tá na miasa Petri déanta as 3.3 gloine borosilicate i gcomhréir le ceanglais HG/T 3115.
Sonraíocht Táirge
Ainm Táirge | Mias petri gloine 100mm |
Trastomhas an chlúdaigh | ≈103mm |
Trastomhas bun | 100mm |
Airde an chlúdaigh | 18±2mm |
Airde bun | 20±1.5mm |
Tiús | 1.2~2mm |
Friotaíocht uisce | HGB2 |
Comhéifeacht leathnú sreang te (20 céim ~ 300 céim) | Níos lú ná nó cothrom le 7.5x10-6K-1 |
Teocht turraing teasa | Níos mó ná nó cothrom le 110 céim |
● Difríocht airde balla mhias
Ní bheidh sonraíochtaí os cionn 90 mm níos mó ná 1.3 mm.
● Eitleán mhias Petri
Ní bheidh an dromchla seachtrach dronnach. Beidh maoile an dromchla istigh níos lú ná nó cothrom le 1.5
● Riachtanais chuma mhias Petri locht
Ní cheadaítear boilgeoga tanaí craiceann, boilgeoga beaga dlúth, stripes mí-ordúil, stripes bíseach, scoilteanna pléasctha agus lochtanna soiléire eile a bheith ann.
● Riachtanais mheaitseála bun agus clúdach mhias Petri
Tar éis bun agus clúdach an mhias petri a bheith feistithe, níl imeall an chlúdaigh níos lú ná 2mm ó phlána seachtrach bun an phláta.
Iarratas
Is féidir mias petri gloine a úsáid i saotharlanna chomh maith le teagasc. Úsáidtear miasa Petri go forleathan sa bhitheolaíocht chun baictéir, múnlaí agus daoine eile a chothú; is féidir é a úsáid freisin i gceimic, talmhaíocht, feithideolaíocht agus daoine eile.

Rialú Cáilíochta

Pacáil, Stóráil agus Iompar
● Pacáiste
Tá miasa petri gloine 100mm pacáilte i cartán sábháilte ar féidir 120 píosa miasa petri gloine 100mm a bheith ann; i méid 49x36x25cm; i meáchan NW 12kg, GW 14kg. Déanfar na táirgí a phacáil i gcartáin roctha i gcomhréir le GB/T 6543; Ba chóir spásaire a chur idir bun agus clúdach an mhias Petri; Comhlíonfaidh an pacáil seachtrach forálacha ábhartha GB/T 191; Taispeánfar sa phacáil seachtrach ainm an táirge, sonraíocht agus cainníocht, glanmheáchan, ollmheáchan agus toirt agus cinn eile.
● Stóráil
Ba chóir táirgí a stóráil laistigh tar éis pacáistiú, níor chóir go mbeadh airde cruachta níos mó ná 10 sraith, níor chóir go mbeadh siad i dteagmháil le haigéad láidir, alcaile láidir, clóiríd agus substaintí ceimiceacha eile.
● Iompar
Is féidir an táirge seo a iompar ar aon mhodh iompair, níor chóir go gcaithfí luchtú agus díluchtú.

CC
1. Cé mhéad cineál mias Petri?
Is féidir linn miasa petri plaisteacha agus gloine a sholáthar i méideanna éagsúla.
2. An féidir leat seirbhís saincheaptha a sholáthar?
Cinnte. Is féidir linn LOGO saincheaptha, pacáiste agus daoine eile a sholáthar.
3. Cén fáth a roghnaíonn tú?
Taithí mhaith i saotharlanna. Tá foireann theicniúil ghairme agus foireann díolacháin againn. Cinnteoimid cáilíocht na dtáirgí; is cúram dúinn gach custaiméir; déanaimid níos mó geallúintí a bhaineann le dearbhú cáilíochta agus oibríocht.
Clibeanna Te: mias petri gloine saotharlainne 100mm, an tSín, soláthróirí, monaróirí, monarcha, saincheaptha, mórdhíola, praghas, pricelist, sampla saor in aisce










